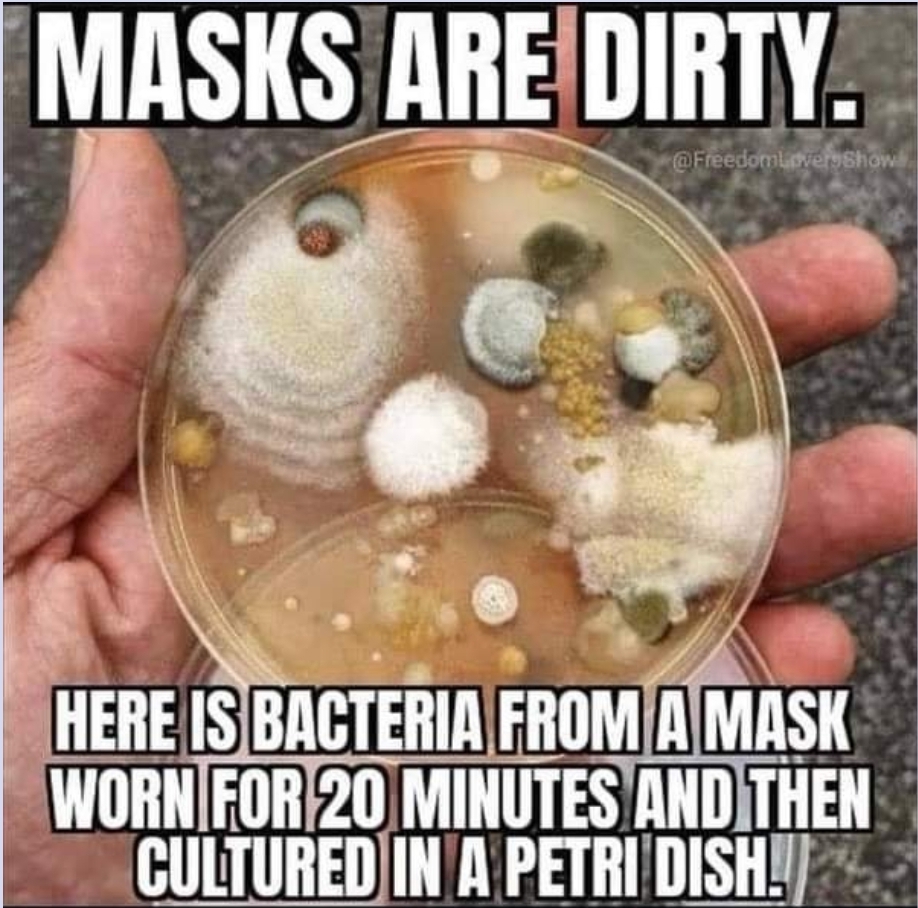

Dimensions of The Human Soul
Let’s talk about dimensions.
A lot of people seem to be confused about what dimension we are in. Let me help: we are in the third dimension.
We are not in the fourth dimension. Yet.
Each dimension has 12 overtones in between. All of this is based on sound (frequency). The higher your vibrational level, the more you resonate with the upward direction of these overtones. The lower, the more dense you are.
Fear and hatred and negative emotions are anchors to keep you in a lower vibrational frequency. Hence, you find yourself tethered to the lower dimensions like the third we are in right now.
There are a total of 144 dimensions to the human soul.
Each one is a step towards the next.
In order to go from one dimension to the next, you have to travel first through the 12 overtones between dimensions.
Those of us who are seeking forward progress, are nearer to the 10th, 11th and 12th overtones that lead to the fourth dimension.
In 4D, the physical body is still in existence. But the vibration of our existence changes. Our physical appearance is different, the world looks different and even the colors that we see are different. This shift doesn’t just happen on its own. It takes work, sobriety, and concentration among other factors.
The fifth dimension is a whole 12 overtones away from the fourth. That means, you have to travel through each step like a ladder if you will, to arrive at the fifth, like you did from the third to the fourth.
Yogic and Eastern teachings as well as some sacred forms of other hidden schools of this sort of soul evolution can teach you these things. The most important component is your willingness to learn.
Seek and ye shall find.
Most lower vibrational creatures cannot enter into the higher dimensions (above 3D and its overtones) because they operate out of fear and negativity. They are not allowed to enter, by cosmic law, states of higher vibrational frequencies with hatred and fear in their hearts. These folks and beings don’t get to pass go, don’t get to collect, and really, their final destination is straight to a self-inflicted prison of ones own mental state and hence, soul.
Another issue is drugs and alcohol. High people and drunk people who are using substances to dim their reality don’t get to go either.
At least not until they stop this type of abuse, addiction and behavior.
You can lie to yourself all you want, but the rules are the rules. You don’t get to change them and no one is going to make you the exception.
All (hu)man(s) are created equal. But not every soul gets to ascend. And no one gets to skip or cut the line.
Another frightening, lofty and truly egotistical misconception is the notion that one gets to go from 3D to 5D. Laughable! This is the same thing as saying that you are 12 and your will be 14. You don’t get to skip a year, any overtones, or any dimensions on your soul’s journey.
You have to do the work and follow the rules. There are very specific rules that cannot be broken in order for one to follow the righteous path, cleanse the soul and ascend accordingly.
All of these people talking about how they are leaving 3D to 5D are misguided and spreading misinformation whether knowingly or not.
So watch who you follow.
Careful who and what you let into the temple of your mind. People who are telling you crazy things are, well crazy until they are proven to be correct.
A lot of knowledge has been hidden from us for a reason: to keep us dumbed down and mind controlled.
Imagine how you feel taking to someone who thinks they know more than you, but they don’t.
You can’t converse with them. You have to nod your head and get away as soon as possible.
Don’t be a part of The Great Mistakening.
Open your mind and stop being indoctrinated by their matrix.
You are a sovereign child of the Most High.
You are a very special being. You are capable of so much beyond your current controlled understanding.
You are indeed ascending every moment as you seek truth and not lies and act in faith to the Almighty.
Use your heart and not your mind to guide you.
To recap: you are in 3D now moving into 4D.
(And for those of you who think the evil reptiles and evil beings live in 4D, this is not correct. Like we said above all life forms operating on fear and hatred are stuck in lower vibrational/dimensional levels which is 3D and below. They are kicked out of of any higher vibrational levels as they sink with the hatred and sickness as they are lower vibrational entities.)
5D is formless. You are no longer in a human meat suite. And so on and so on.
No one gets a free pass unless they do the work.
The sheep living in fear and triple (or single) masking, and getting the jab are not ascending. Most likely, they are all going to die as a result of their sheepish choices. The best they can hope for is to become robots of the matrix. They actually already are. They are Blood Currency the cabal gets to keep. The ultimate deal. And all by their own free choice.
And as for you reading this article?
The Choice To Know Will Be Yours.
🤔 🤔 🤔
THREADS AND POSTS



From Dr. Tenpenny on Telegram: https://t.me/DrTenpenny



Look at these shitstains. All of them have been caught. There was a deal made early on with the media and Potus: a blackout to not demean their names publicly (until all trials are complete) and they cooperate. This info was given to me by a high level operative early on in 2016. These people are all sick, vile and will burn. Shitstains. Thank you Bunny for these posts and reminders of The Filth And Scum Of Pedowood


Listen to what Potus has to say about the Fake Oscars:
Statement by Donald J. Trump, 45th President of the United States of America
What used to be called The Academy Awards, and now is called the “Oscars”—a far less important and elegant name—had the lowest Television Ratings in recorded history, even much lower than last year, which set another record low. If they keep with the current ridiculous formula, it will only get worse—if that’s possible. Go back 15 years, look at the formula they then used, change the name back to THE ACADEMY AWARDS, don’t be so politically correct and boring, and do it right. ALSO, BRING BACK A GREAT HOST. These television people spend all their time thinking about how to promote the Democrat Party, which is destroying our Country, and cancel Conservatives and Republicans. That formula certainly hasn’t worked very well for The Academy!
Follow the Potus account on Telegram: https://t.me/real_DonaldJTrump
Remember when Ricky Gervais handed the entire Pedowood shitshow their ass with No Vaseline? 👈🏼 [Watch it here] Live? From the Oscars? He clearly said it was the last Oscars. Gervais was working with our White Hats. He was right. The new Oscars is all CGI with some live “actors” acting like the other actors.
This thing is wearing a half body mask because the real one has been terminated.

The OSCARS were FAKE. Its all CGI and once again, You Are Watching a Show 🎥🍿 Look at this little inverted hermaphrodite Nubhanson. He’s so disgusting. Burn CRETIN BURN!
The woman behind shim disappears.
SCARRED JOHANDSON is a DUDE. With a full on NUB. Years will go by before the idiots understand this all. Then again, they may all be dead from the Vax by then. Art by Bill @Swellbs on GAB) Make sure to (re)visit the article called Trannygate




LINKS AND ARTICLES
Notables by @BenjaminABock on GAB:
Ghislaine pleads not guilty to sex trafficking https://wearethene.ws/notable/218150
FBI Finally Releases Records on Murdered DNC Analyst Seth Rich https://wearethene.ws/notable/218126
Anti vaxx passport protests happening all over the world https://www.bitchute.com/video/5h9bkBL2VFLS/
Wuhan lab connected to chinese military, docs reveal https://wearethene.ws/notable/218219
Rna vaccines and the risk of Prion Disease [ Peer Reviewed ] https://wearethene.ws/notable/218216
ProjectVeritas JamesOkeeffe Winning >> twitter and Cnn https://wearethene.ws/notable/218214
Huge/P3nt4gon/D0d/Ipadress/ thread https://wearethene.ws/notable/218167
Ipaddress d0d dig 2 https://wearethene.ws/notable/218168
Dormantipaddresses d0d dig 3 https://wearethene.ws/notable/218166
End of Notables by Benjamin. Thank you Ben!
VIDEOS
Project Looking Glass QAnon / Marina Jacobi Quantum information of why is happening
Listen to this nurse. She is absolutely correct. They are the enemy. They don’t GAF what happens to us. #JabbersAreIdiots
NEW FBI DOCS REVEAL SETH RICH MURDER PLOT!
What Does Bill Gates Plan to Do After He Vaccinates the World Population?
ART & PHOTOGRAPHY
FUNNIES & MEMES
Today’s Meme Gallery

Bill’s Hall of Infamemes
Did you know that this shim hates its feet? Lots of cosmetic surgery can turn anything into anything. Another inversion.





TUNE OF THE DAY
Note to all visitors:
Please make sure to subscribe to this blog by scrolling to the bottom and clicking “Follow” where you will be prompted to enter your email address which will remain private and your information is not shared with advertisers (there are none). This is a free service bought to you by patriots. God bless you and Godspeed! 🙏🏼 ♥️ ⚖️
~ Dilara 04.27.21
NOTE: Sometimes WP lists these posts on the wrong dates due to the fact that their servers seem to be located in the UK or at least run on UK time. The date that appears after my name in each post is the correct date of each daily post. Thank you for your understanding.
You can follow me on GAB: @DilaraEsengil or Twitter @EsengilDilara (my old account is suspended #StayTheCourse: Twitter Suspension) but I’m mostly here on the blog. ♥️
Categories: Uncategorized








Love your work, and thank you for getting to/at the truth.
Wow so timely!!! Thanks for this!
I can’t help ask the 3D question. What is with the boot? Some ritual?
The boot? An incognito ankle monitor. Think: PRISON
Ahh!! Of course. After seeing all their black eyes I couldn’t figure out what the boot was. Your work and passion is amazing!!!! I found your website a year ago and couldn’t believe my eyes – I would pour over your posts and twitter . So good to not be so obsessed now but I really appreciate all your emails. Thank you from Katie in NZ
Dilara,
Thank you for all the work you do! I first heard you on Linda’s channel and the two of you together are the best! And, from one believer to another, thanks for representing!